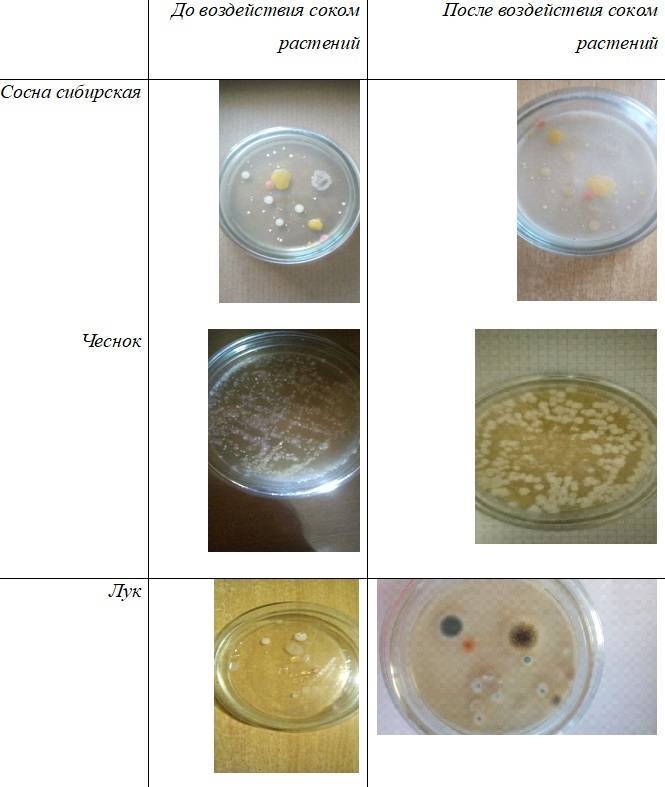
sfq7pRaMwu8.jpg sfq7pRaMwu8.jpg

Ученик одной из школ Красноярска Макар Трощук провел домашний эксперимент и выявил самые грязные предметы. Школьник решил выяснить, какие предметы больше других опасны в отношении распространения микробов. Также ученик школы №137 захотел проверить эффективность народных средств в борьбе с микробами.
Для этого Макар организовал домашнюю лабораторию и вырастил микробы в питательной среде. Для её создания он отварил картофель, процедил отвар через марлю и растворил в нём агар-агар на водяной бане.
Проверял он поверхности мобильного телефона и игрушек. Именно их он сам касается чаще всего. После стерилизации и охлаждения импровизированной чашек Петри он поместил в них образцы смывов с телефона, ручки и конструктора.
Пятна плесени на образце с телефона появились уже на следующий день. В образце с шариковой ручки несколько жёлтых и розовых пятен проявились на второй день. На третий день плесень разрослась в первой чаше окончательно, и продолжала множится во второй и третьей.
После добавления в чаши сока чеснока, лука и хвои сосны школьник отметил прекращение роста микроорганизмов в питательной среде. Наиболее эффективными оказались чеснок и хвоя.
Фото: vk.com/krasnoyarskrf



















